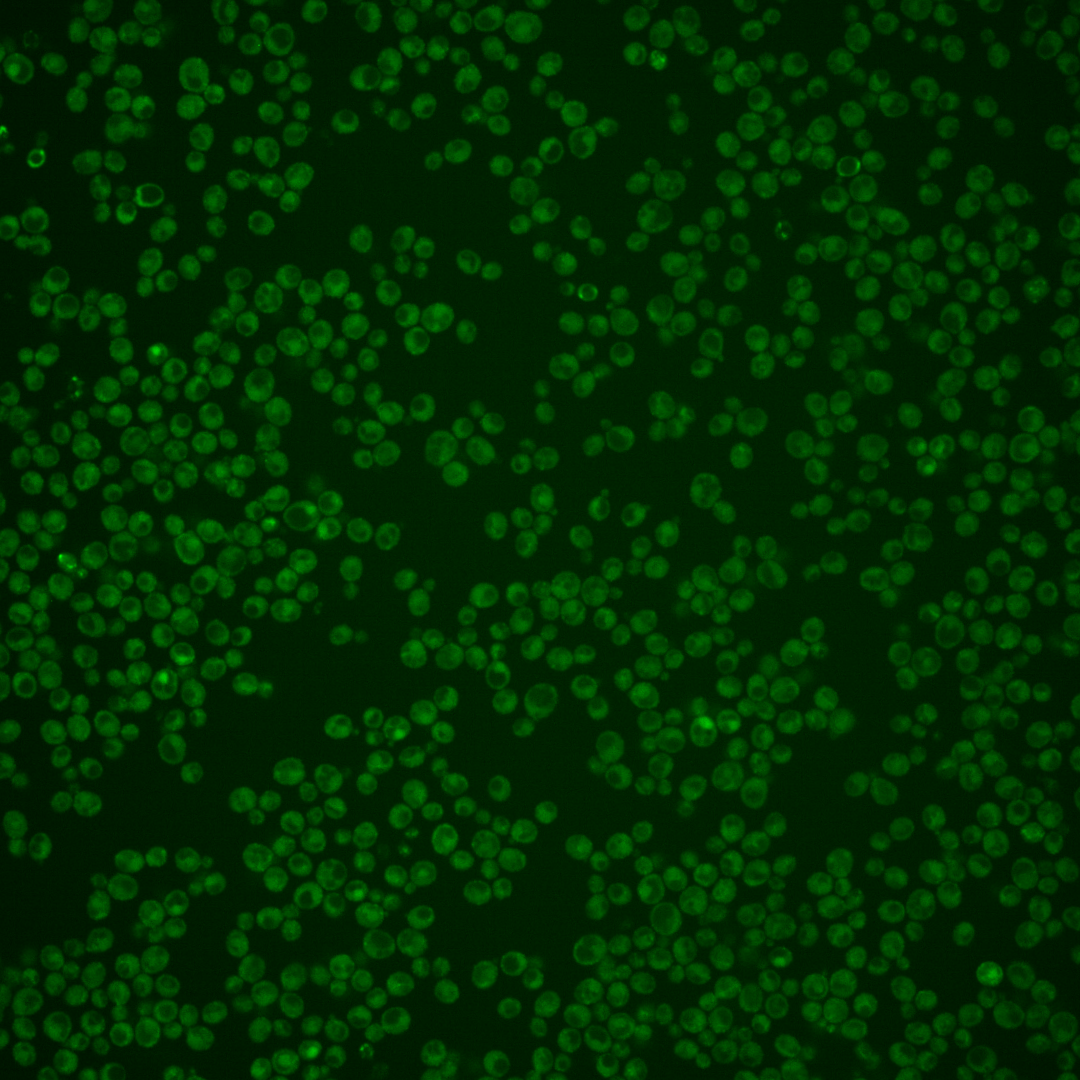
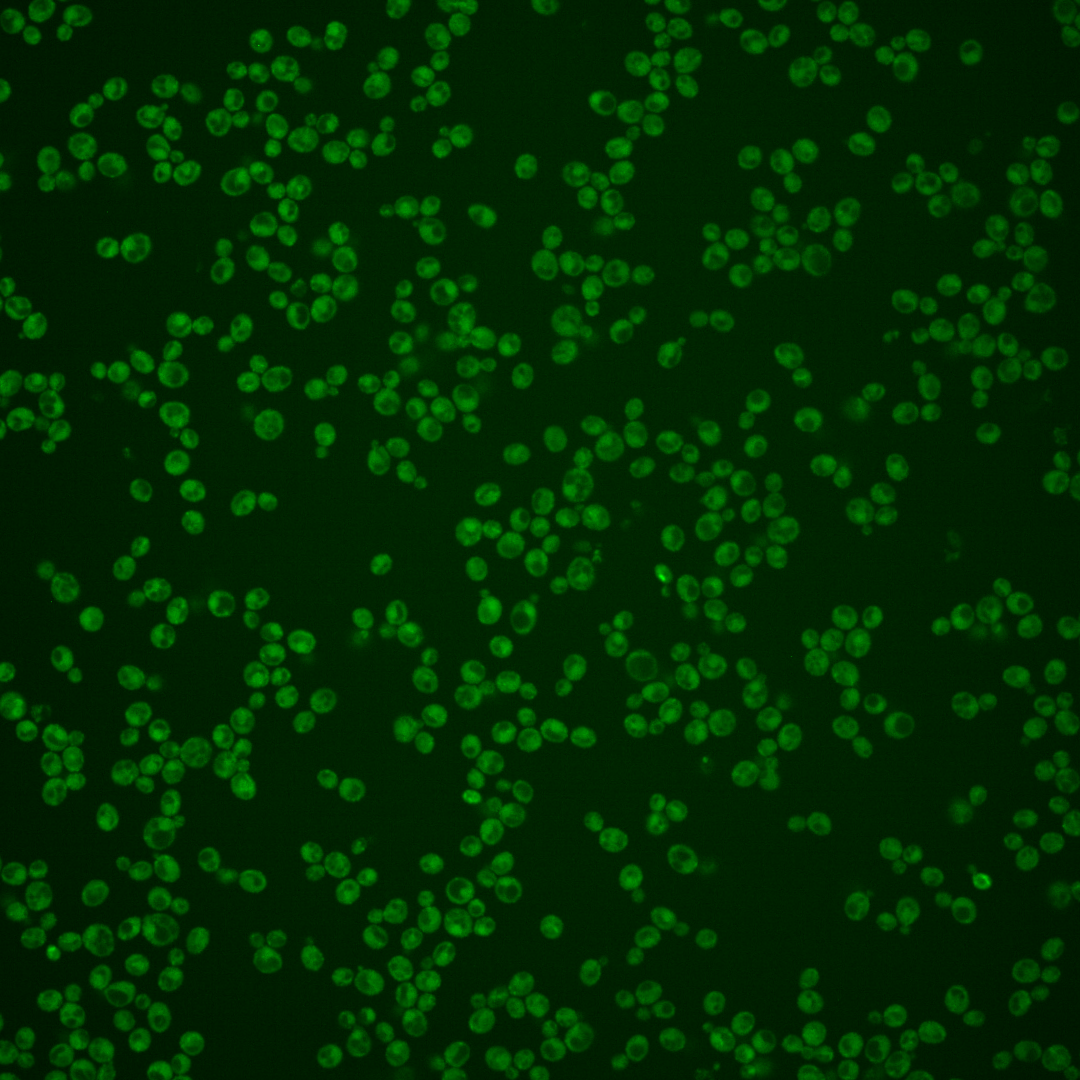
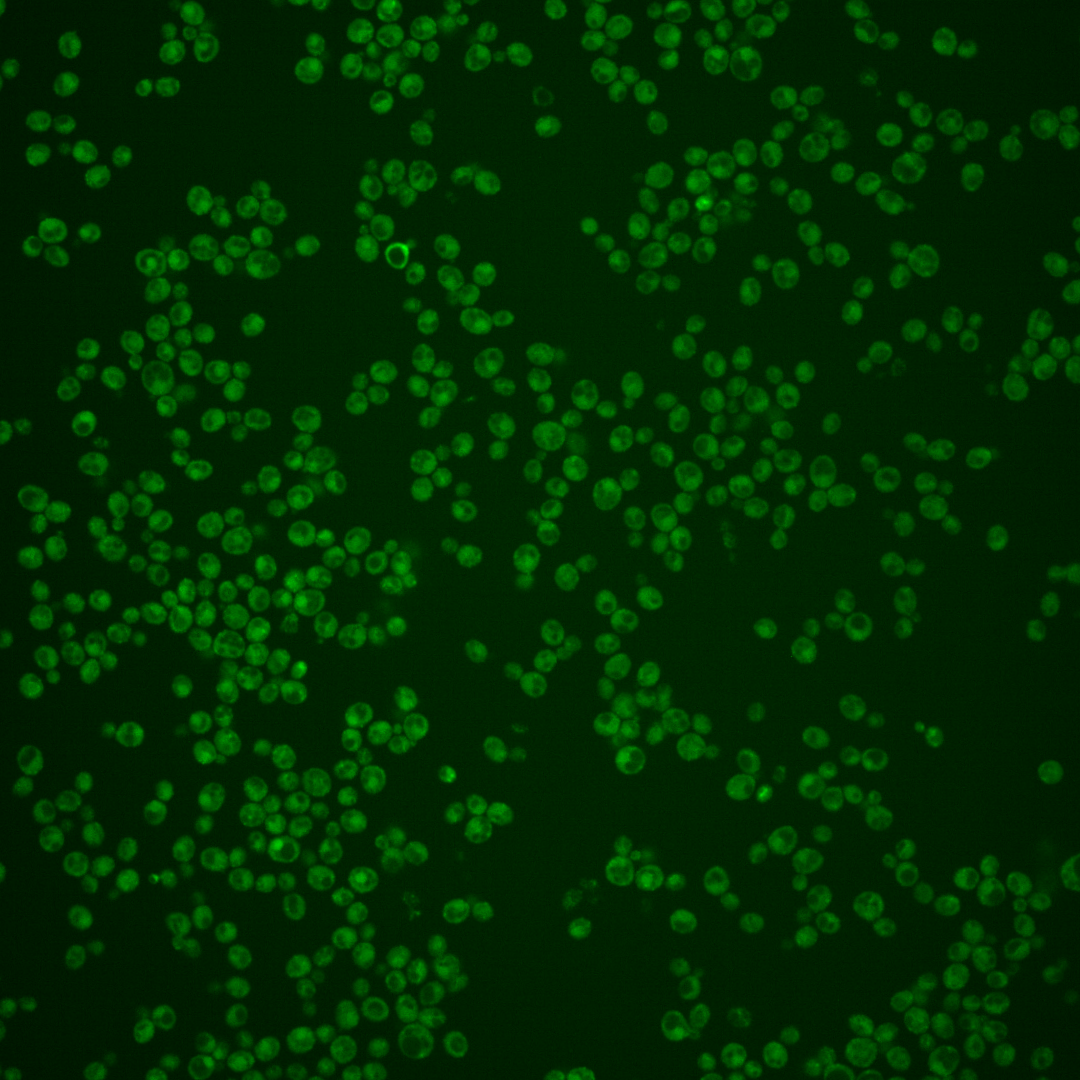
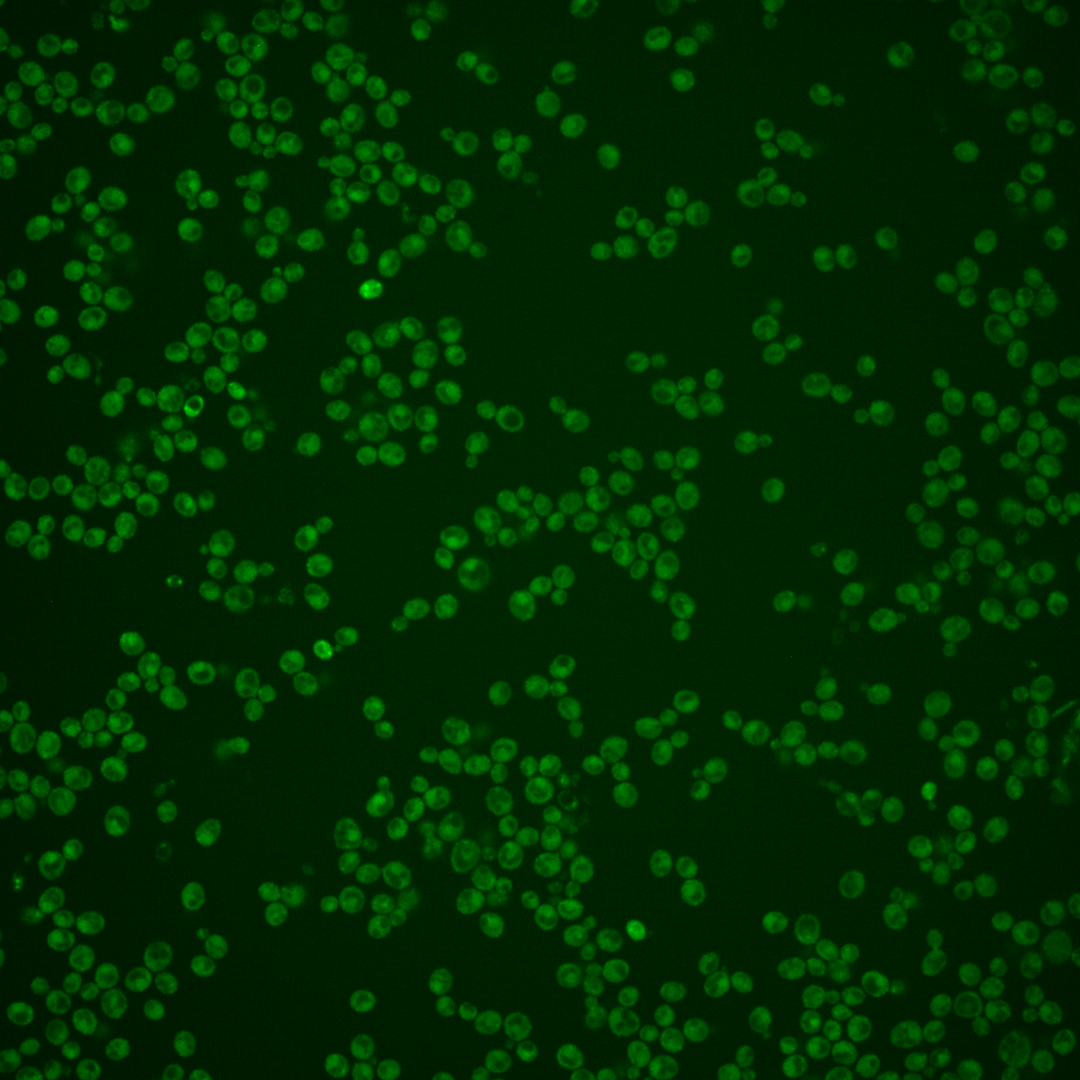

| Standard name | |
|---|---|
| Human Ortholog | |
| Description | Scaffold subunit of the Hrd1p ubiquitin ligase; also promotes ligase oligomerization; involved in ER-associated protein degradation (ERAD); interacts with the U1 snRNP-specific protein, Snp1p |
Micrographs




















































































Sub-cellular Localization
Yeast GFP Assignment
Protein Abundance
Localization Change
External localization resources
| ensLOC | DeepLoc | |||||||||||||||||||||||
|---|---|---|---|---|---|---|---|---|---|---|---|---|---|---|---|---|---|---|---|---|---|---|---|---|
| Localization | WT1 | WT2 | WT3 | RAP60 | RAP140 | RAP220 | RAP300 | RAP380 | RAP460 | RAP540 | RAP620 | RAP700 | HU80 | HU120 | HU160 | rpd3Δ_1 | rpd3Δ_2 | rpd3Δ_3 | WT1 | WT2 | WT3 | AF100 | AF140 | AF180 |
| Cortical Patches | 7 | 16 | 3 | 2 | 1 | 2 | 2 | 0 | 0 | 0 | 0 | 0 | 1 | 2 | 1 | 2 | 16 | 2 | 10 | 36 | 19 | 24 | 51 | 47 |
| Bud | 6 | 10 | 2 | 1 | 2 | 1 | 4 | 1 | 0 | 0 | 4 | 0 | 2 | 1 | 1 | 0 | 7 | 0 | 1 | 2 | 2 | 1 | 3 | 1 |
| Bud Neck | 1 | 1 | 2 | 0 | 1 | 1 | 0 | 3 | 0 | 0 | 0 | 0 | 0 | 0 | 1 | 0 | 4 | 0 | 2 | 7 | 5 | 4 | 11 | 13 |
| Bud Site | 0 | 0 | 0 | 0 | 0 | 0 | 0 | 0 | 0 | 0 | 0 | 0 | 0 | 0 | 0 | 0 | 0 | 0 | – | – | – | – | – | – |
| Cell Periphery | 0 | 7 | 10 | 10 | 11 | 3 | 3 | 4 | 0 | 3 | 0 | 1 | 12 | 5 | 8 | 6 | 6 | 1 | 5 | 13 | 16 | 16 | 40 | 31 |
| Cytoplasm | 45 | 142 | 153 | 113 | 137 | 139 | 203 | 216 | 92 | 85 | 49 | 30 | 126 | 199 | 272 | 49 | 57 | 16 | 17 | 57 | 38 | 18 | 20 | 16 |
| Endoplasmic Reticulum | 32 | 45 | 2 | 2 | 7 | 8 | 7 | 1 | 3 | 4 | 0 | 0 | 15 | 14 | 4 | 5 | 2 | 3 | 60 | 77 | 39 | 32 | 73 | 55 |
| Endosome | 0 | 1 | 0 | 0 | 0 | 2 | 2 | 0 | 0 | 0 | 0 | 0 | 2 | 0 | 0 | 0 | 0 | 2 | 2 | 9 | 2 | 1 | 4 | 3 |
| Golgi | 0 | 0 | 0 | 0 | 0 | 0 | 0 | 0 | 0 | 0 | 0 | 0 | 0 | 0 | 0 | 1 | 0 | 0 | 0 | 2 | 1 | 0 | 1 | 4 |
| Mitochondria | 12 | 7 | 5 | 16 | 17 | 22 | 44 | 31 | 43 | 50 | 49 | 23 | 3 | 3 | 1 | 8 | 4 | 4 | 17 | 55 | 57 | 29 | 49 | 34 |
| Nucleus | 0 | 2 | 0 | 1 | 0 | 1 | 3 | 2 | 3 | 2 | 1 | 0 | 0 | 0 | 2 | 2 | 3 | 0 | 0 | 0 | 0 | 0 | 0 | 0 |
| Nuclear Periphery | 0 | 0 | 0 | 0 | 0 | 0 | 1 | 0 | 0 | 3 | 0 | 0 | 0 | 1 | 1 | 0 | 0 | 0 | 0 | 1 | 2 | 0 | 0 | 0 |
| Nucleolus | 0 | 0 | 0 | 0 | 0 | 0 | 1 | 0 | 1 | 0 | 1 | 0 | 0 | 1 | 0 | 0 | 0 | 0 | 0 | 0 | 0 | 0 | 0 | 0 |
| Peroxisomes | 0 | 0 | 0 | 0 | 0 | 0 | 0 | 0 | 0 | 0 | 0 | 0 | 0 | 0 | 0 | 0 | 0 | 0 | 0 | 1 | 0 | 0 | 0 | 0 |
| SpindlePole | 0 | 0 | 1 | 0 | 1 | 1 | 1 | 2 | 0 | 1 | 0 | 0 | 0 | 0 | 1 | 0 | 0 | 0 | 0 | 1 | 0 | 0 | 0 | 1 |
| Vac/Vac Membrane | 0 | 6 | 2 | 1 | 2 | 1 | 1 | 2 | 1 | 2 | 0 | 0 | 0 | 1 | 2 | 3 | 2 | 3 | 7 | 12 | 7 | 4 | 14 | 11 |
| Unique Cell Count | 87 | 212 | 167 | 130 | 163 | 166 | 241 | 236 | 120 | 128 | 80 | 46 | 146 | 218 | 283 | 65 | 81 | 26 | 128 | 285 | 199 | 141 | 280 | 229 |
| Labelled Cell Count | 103 | 237 | 180 | 146 | 179 | 181 | 272 | 262 | 143 | 150 | 104 | 54 | 161 | 227 | 294 | 76 | 101 | 31 | 128 | 285 | 199 | 141 | 280 | 229 |
Yeast GFP Assignment
Protein Abundance
| Screen | WT1 | WT2 | WT3 | RAP60 | RAP140 | RAP220 | RAP300 | RAP380 | RAP460 | RAP540 | RAP620 | RAP700 | HU80 | HU120 | HU160 | rpd3Δ_1 | rpd3Δ_2 | rpd3Δ_3 | AF100 | AF140 | AF180 |
|---|---|---|---|---|---|---|---|---|---|---|---|---|---|---|---|---|---|---|---|---|---|
| Mean Cell GFP Intensity (1e-4) | 5.0 | 4.9 | 5.3 | 5.1 | 5.5 | 4.4 | 4.6 | 4.8 | 4.3 | 4.3 | 3.8 | 3.9 | 5.1 | 5.2 | 5.1 | 6.7 | 6.9 | 6.3 | 4.7 | 4.9 | 5.5 |
| Std Deviation (1e-4) | 0.6 | 0.7 | 0.7 | 1.4 | 1.1 | 1.2 | 1.4 | 1.7 | 1.9 | 1.9 | 1.7 | 0.8 | 1.1 | 1.3 | 1.5 | 1.5 | 1.6 | 1.4 | 1.1 | 1.6 | 1.8 |
| Intensity Change (Log2) | – | – | – | -0.04 | 0.05 | -0.27 | -0.21 | -0.14 | -0.3 | -0.28 | -0.48 | -0.43 | -0.04 | -0.02 | -0.03 | 0.35 | 0.38 | 0.25 | -0.17 | -0.1 | 0.06 |
Localization Change
| Localization | RAP60 | RAP140 | RAP220 | RAP300 | RAP380 | RAP460 | RAP540 | RAP620 | RAP700 | HU80 | HU120 | HU160 | rpd3Δ_1 | rpd3Δ_2 | rpd3Δ_3 |
|---|---|---|---|---|---|---|---|---|---|---|---|---|---|---|---|
| Cortical Patches | 0 | 0 | 0 | 0 | 0 | 0 | 0 | 0 | 0 | 0 | 0 | 0 | 0 | 5.0 | 0 |
| Bud | 0 | 0 | 0 | 0 | 0 | 0 | 0 | 0 | 0 | 0 | 0 | 0 | 0 | 0 | 0 |
| Bud Neck | 0 | 0 | 0 | 0 | 0 | 0 | 0 | 0 | 0 | 0 | 0 | 0 | 0 | 0 | 0 |
| Bud Site | 0 | 0 | 0 | 0 | 0 | 0 | 0 | 0 | 0 | 0 | 0 | 0 | 0 | 0 | 0 |
| Cell Periphery | 0.6 | 0.3 | 0 | 0 | 0 | 0 | 0 | 0 | 0 | 0.8 | -1.9 | -1.7 | 0 | 0.4 | 0 |
| Cytoplasm | -1.3 | -2.1 | -2.2 | -2.2 | 0 | -3.5 | -5.4 | -5.8 | -4.6 | -1.5 | -0.1 | 2.0 | -3.3 | -4.4 | -4.3 |
| Endoplasmic Reticulum | 0 | 0 | 0 | 0 | 0 | 0 | 0 | 0 | 0 | 3.5 | 2.5 | 0 | 0 | 0 | 0 |
| Endosome | 0 | 0 | 0 | 0 | 0 | 0 | 0 | 0 | 0 | 0 | 0 | 0 | 0 | 0 | 0 |
| Golgi | 0 | 0 | 0 | 0 | 0 | 0 | 0 | 0 | 0 | 0 | 0 | 0 | 0 | 0 | 0 |
| Mitochondria | 3.1 | 2.7 | 0 | 0 | 0 | 0 | 0 | 0 | 0 | 0 | 0 | 0 | 0 | 0 | 0 |
| Nucleus | 0 | 0 | 0 | 0 | 0 | 0 | 0 | 0 | 0 | 0 | 0 | 0 | 0 | 0 | 0 |
| Nuclear Periphery | 0 | 0 | 0 | 0 | 0 | 0 | 0 | 0 | 0 | 0 | 0 | 0 | 0 | 0 | 0 |
| Nucleolus | 0 | 0 | 0 | 0 | 0 | 0 | 0 | 0 | 0 | 0 | 0 | 0 | 0 | 0 | 0 |
| Peroxisomes | 0 | 0 | 0 | 0 | 0 | 0 | 0 | 0 | 0 | 0 | 0 | 0 | 0 | 0 | 0 |
| SpindlePole | 0 | 0 | 0 | 0 | 0 | 0 | 0 | 0 | 0 | 0 | 0 | 0 | 0 | 0 | 0 |
| Vacuole | 0 | 0 | 0 | 0 | 0 | 0 | 0 | 0 | 0 | 0 | 0 | 0 | 0 | 0 | 0 |
External localization resources
Images






























Protein Concentration and Protein Localization Data
| R1 | R2 | R3 | ||||||||||||||||
|---|---|---|---|---|---|---|---|---|---|---|---|---|---|---|---|---|---|---|
| G1 Pre-START | G1 Post-START | S/G2 | Metaphase | Anaphase | Telophase | G1 Pre-START | G1 Post-START | S/G2 | Metaphase | Anaphase | Telophase | G1 Pre-START | G1 Post-START | S/G2 | Metaphase | Anaphase | Telophase | |
| Concentration | 2.7841 | 3.2328 | 2.8649 | 2.8599 | 2.7965 | 3.1198 | 1.575 | 1.5217 | 1.4842 | 1.0327 | 1.7453 | 1.3501 | 0.7209 | 0.2326 | 0.3163 | -0.3114 | 0.0307 | 0.6181 |
| Actin | 0.032 | 0.0217 | 0.0158 | 0.0259 | 0.0222 | 0.0325 | 0.0529 | 0.0157 | 0.0532 | 0.0256 | 0.029 | 0.0182 | 0.0624 | 0.015 | 0.0332 | 0.0038 | 0.0813 | 0.0039 |
| Bud | 0.0005 | 0.0004 | 0.0009 | 0.0009 | 0.0003 | 0.001 | 0.0017 | 0.0026 | 0.0015 | 0.0019 | 0.0019 | 0.0011 | 0.0013 | 0.0002 | 0.0011 | 0.0002 | 0.0004 | 0.0004 |
| Bud Neck | 0.0027 | 0.0014 | 0.0022 | 0.0212 | 0.0031 | 0.0458 | 0.0114 | 0.0032 | 0.0131 | 0.0038 | 0.0232 | 0.026 | 0.0046 | 0.0009 | 0.0044 | 0.0012 | 0.0022 | 0.0317 |
| Bud Periphery | 0.001 | 0.001 | 0.0037 | 0.0031 | 0.001 | 0.0033 | 0.0055 | 0.0061 | 0.0036 | 0.0072 | 0.0048 | 0.0065 | 0.0019 | 0.0005 | 0.0029 | 0.0004 | 0.001 | 0.0008 |
| Bud Site | 0.0093 | 0.0333 | 0.01 | 0.0021 | 0.0008 | 0.0024 | 0.0156 | 0.0899 | 0.0304 | 0.0017 | 0.0181 | 0.0023 | 0.0347 | 0.0266 | 0.0105 | 0.001 | 0.0012 | 0.0115 |
| Cell Periphery | 0.011 | 0.0203 | 0.0135 | 0.0065 | 0.0092 | 0.009 | 0.0093 | 0.0155 | 0.008 | 0.0271 | 0.0046 | 0.0047 | 0.0106 | 0.0079 | 0.0052 | 0.0016 | 0.0019 | 0.0024 |
| Cytoplasm | 0.3538 | 0.4394 | 0.4291 | 0.3248 | 0.4427 | 0.4679 | 0.2971 | 0.4553 | 0.3616 | 0.3469 | 0.3014 | 0.4694 | 0.225 | 0.3435 | 0.4408 | 0.4061 | 0.4602 | 0.4642 |
| Cytoplasmic Foci | 0.0439 | 0.0123 | 0.0281 | 0.0417 | 0.0306 | 0.034 | 0.0425 | 0.0192 | 0.045 | 0.0164 | 0.072 | 0.0405 | 0.0709 | 0.0335 | 0.0251 | 0.0478 | 0.0953 | 0.0134 |
| Eisosomes | 0.0019 | 0.0013 | 0.0024 | 0.0015 | 0.0009 | 0.0014 | 0.0027 | 0.0019 | 0.002 | 0.0011 | 0.0015 | 0.0008 | 0.001 | 0.0008 | 0.0008 | 0.0005 | 0.0013 | 0.0002 |
| Endoplasmic Reticulum | 0.1236 | 0.0915 | 0.1068 | 0.1451 | 0.1303 | 0.087 | 0.1621 | 0.1069 | 0.157 | 0.2287 | 0.0433 | 0.1536 | 0.0933 | 0.1158 | 0.0907 | 0.0667 | 0.1491 | 0.0998 |
| Endosome | 0.029 | 0.0083 | 0.0285 | 0.0128 | 0.0244 | 0.016 | 0.0605 | 0.016 | 0.0415 | 0.0252 | 0.0985 | 0.0271 | 0.0369 | 0.0276 | 0.0231 | 0.0374 | 0.0103 | 0.0139 |
| Golgi | 0.0112 | 0.0035 | 0.0108 | 0.0096 | 0.0048 | 0.0064 | 0.0236 | 0.0053 | 0.0168 | 0.0095 | 0.024 | 0.0107 | 0.0085 | 0.0067 | 0.0087 | 0.007 | 0.0122 | 0.0035 |
| Lipid Particles | 0.0367 | 0.0087 | 0.0167 | 0.0091 | 0.0048 | 0.0081 | 0.0582 | 0.0134 | 0.0224 | 0.0178 | 0.0398 | 0.0129 | 0.0257 | 0.0169 | 0.0153 | 0.0163 | 0.024 | 0.0098 |
| Mitochondria | 0.0062 | 0.0007 | 0.0105 | 0.0067 | 0.0028 | 0.0043 | 0.0191 | 0.0031 | 0.0114 | 0.004 | 0.0488 | 0.0124 | 0.0071 | 0.0008 | 0.0145 | 0.0018 | 0.0095 | 0.0024 |
| None | 0.3034 | 0.3426 | 0.2964 | 0.3465 | 0.2905 | 0.2559 | 0.1714 | 0.2183 | 0.1976 | 0.2527 | 0.1452 | 0.1797 | 0.319 | 0.3934 | 0.307 | 0.3981 | 0.1296 | 0.3183 |
| Nuclear Periphery | 0.0087 | 0.0045 | 0.007 | 0.0044 | 0.0121 | 0.0023 | 0.0238 | 0.0033 | 0.0078 | 0.0149 | 0.0195 | 0.0061 | 0.0072 | 0.0025 | 0.0029 | 0.002 | 0.0039 | 0.0027 |
| Nucleolus | 0.001 | 0.0004 | 0.0005 | 0.0004 | 0.0004 | 0.0004 | 0.0015 | 0.0026 | 0.0017 | 0.0007 | 0.0018 | 0.0014 | 0.0051 | 0.0003 | 0.0002 | 0.0002 | 0.0002 | 0.0015 |
| Nucleus | 0.0034 | 0.0022 | 0.0024 | 0.0019 | 0.0081 | 0.003 | 0.005 | 0.0063 | 0.0045 | 0.0034 | 0.0039 | 0.0069 | 0.0036 | 0.001 | 0.0015 | 0.0011 | 0.0009 | 0.0022 |
| Peroxisomes | 0.0091 | 0.0004 | 0.0058 | 0.0305 | 0.0032 | 0.0133 | 0.014 | 0.0015 | 0.0057 | 0.0007 | 0.0738 | 0.0037 | 0.0321 | 0.0005 | 0.005 | 0.0009 | 0.0107 | 0.0118 |
| Punctate Nuclear | 0.0072 | 0.0007 | 0.0016 | 0.0008 | 0.0051 | 0.002 | 0.0093 | 0.0078 | 0.0046 | 0.0014 | 0.0037 | 0.0088 | 0.035 | 0.0012 | 0.001 | 0.0014 | 0.0026 | 0.0027 |
| Vacuole | 0.0037 | 0.0052 | 0.0065 | 0.0041 | 0.0025 | 0.0035 | 0.0101 | 0.0058 | 0.0091 | 0.0077 | 0.0318 | 0.0059 | 0.0123 | 0.0042 | 0.0051 | 0.0039 | 0.0017 | 0.0028 |
| Vacuole Periphery | 0.0006 | 0.0003 | 0.001 | 0.0006 | 0.0005 | 0.0005 | 0.0029 | 0.0004 | 0.0017 | 0.0016 | 0.0093 | 0.0013 | 0.0017 | 0.0003 | 0.0009 | 0.0005 | 0.0006 | 0.0003 |
Sequencing Data
| R1 | R2 | |||||||||
|---|---|---|---|---|---|---|---|---|---|---|
| G1 Post-START | S/G2 | Metaphase | Anaphase | Telophase | G1 Post-START | S/G2 | Metaphase | Anaphase | Telophase | |
| Gene Expression | 9.4252 | 12.1485 | 11.9226 | 14.9071 | 12.2202 | 13.5823 | 14.1654 | 16.0459 | 15.7047 | 15.6387 |
| Translational Efficiency | 1.1119 | 0.6244 | 0.8331 | 0.7795 | 0.7616 | 0.8604 | 0.6399 | 0.7161 | 0.8289 | 0.778 |
Hit Data
| Dataset | Hit |
|---|---|
| Protein Concentration | ✘ |
| Protein Localization | ✘ |
| Gene Expression | ✘ |
| Translational Efficiency | ✘ |
Endocytosis
| Temp | Actin Patch (Sac6-tdTomato) | Cortical Patch (Sla1-GFP) | Late Endosome (Snf7-GFP) | Vacuole (Vph1-GFP) |
|---|---|---|---|---|
| 37℃ | ||||
| RT |
Cell Cycle Omics
CYCLoPs (Usa1-GFP)
| Gene / Allele | Actin Patch (Sac6-tdTomato) | Cortical Patch (Sla1-GFP) | Late Endosome (Snf7-GFP) | Vacuole (Sac6-tdTomato) |
|---|
| Gene | Images |
|---|
| Gene | Images |
|---|
Images are not yet available
Images are not yet available